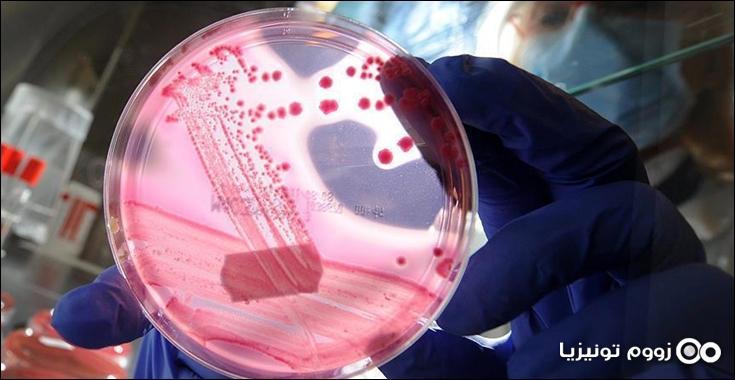

وعقدت اللجنة الوطنية للوقاية ومجابهة الأمراض الوبائية، اليوم، اجتماعا بإشراف وزير الصحة عماد الحمامي، وحضور ممثلي وزارات الدفاع والداخلية والبيئة والفلاحة والتجارة والتربية والتعليم العالي.
وقالت نبيهة برصالي فلفول، في تصريحات إعلامية على هامش الاجتماع، إن هذا ما تم تسجيله إلى الآن، ولكن الرقم قد يكون مرتفعا، لأن 20 بالمئة فقط ممن يصابون بهذا الفيروس تكون لديهم أعراض مثل الحمى والإنفلونزا.
وينتشر فيروس حمى غرب النيل عادة عن طريق البعوض المصاب، ويصاب البعوض بالعدوى عندما تتغذى على دم طيور مصابة.
كما لا تنتقل عدوى هذا الفيروس بين الناس مباشرة، وتزداد خطورته لدى كبار السن والمصابين بمرض فقدان المناعة.
وبحسب المديرة العامة للصحة، فإن "هذا المرض يتفاقم أكثر تزامنا مع التغيرات المناخية ونزول الأمطار والرطوبة وركود المياه التي ترافقها كثرة الحشرات".
وشددت على "ضرورة توخي الوقاية من الأوساخ والتكثيف من النظافة وتفادي انتشار الحشرات".
وفي تصريحات إعلامية على هامش الاجتماع ذاته، أكد وزير الصحة عماد الحمامي أن "اللجنة ستعمل على وضع خطة تتضمن إجراءات عاجلة للوقاية من الأمراض المعدية التي تتنقل بفعل التقلبات الجوية، ومع تواصل الرطوبة، وارتفاع درجات الحرارة".
المصدر : وكالة الأناضول.
